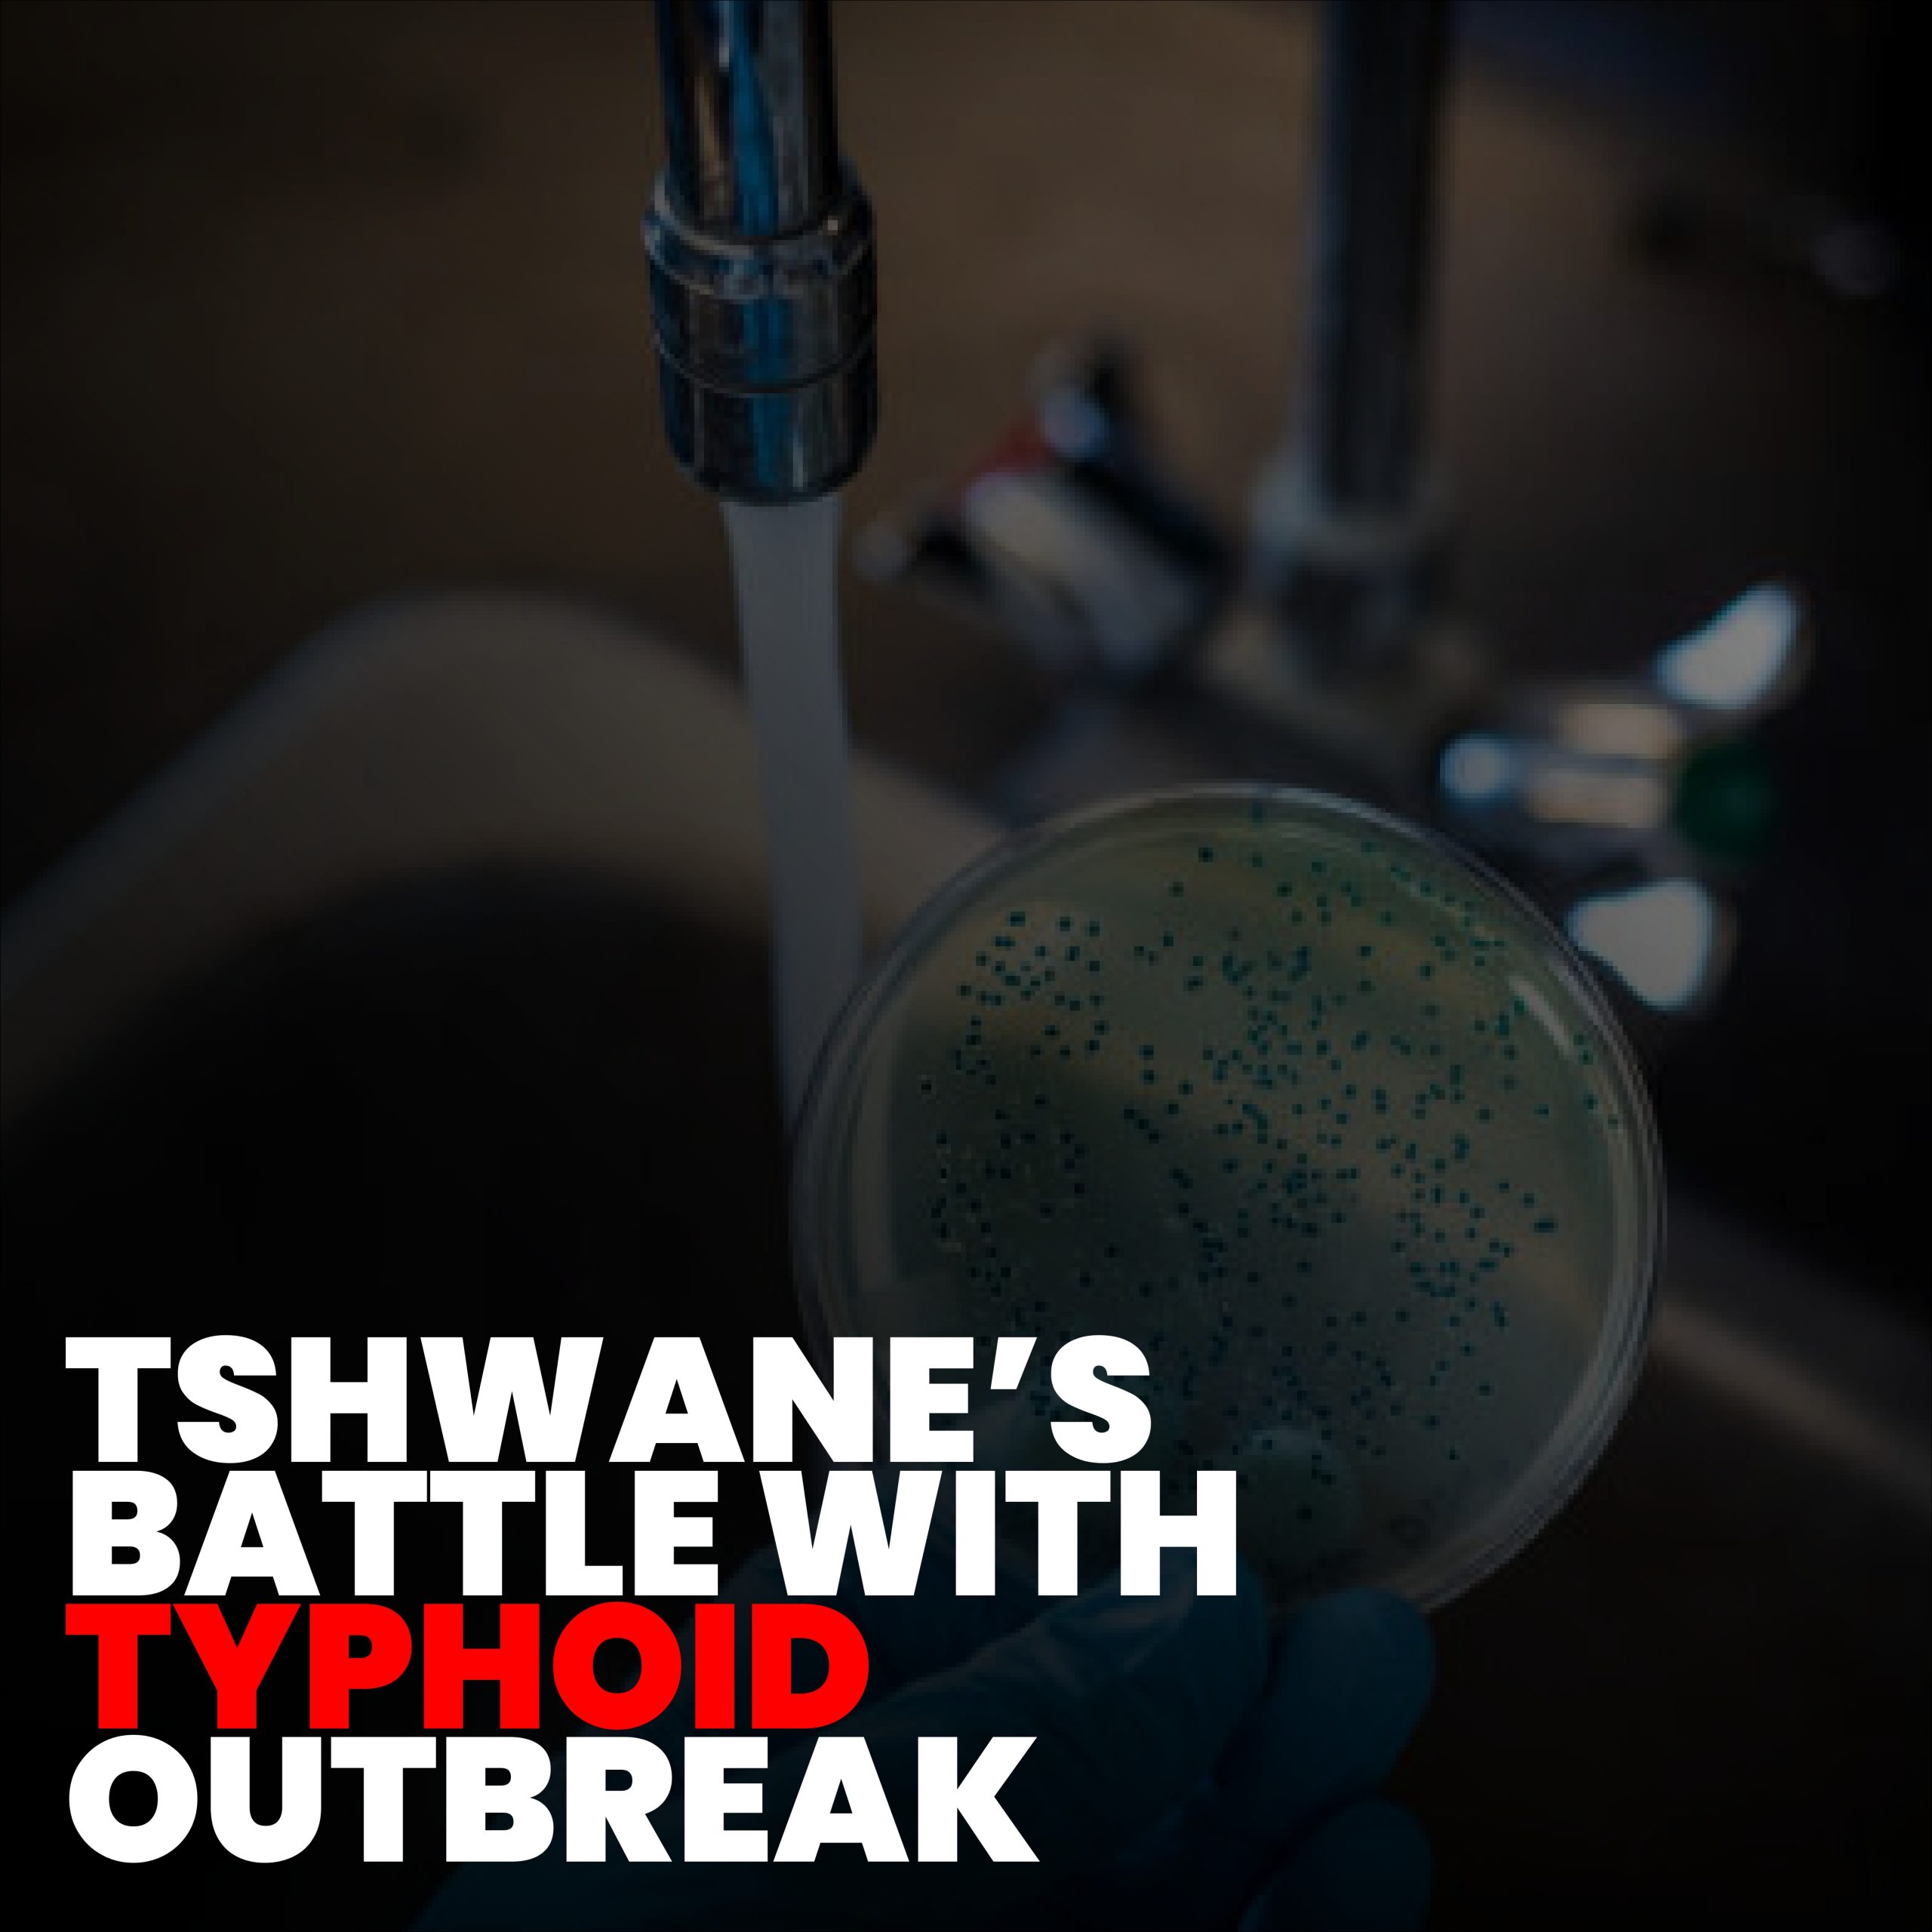
Typhoid Surge: 6 Essential Actions to Combat the Rising Cases in Tshwane

SA Sports Awards Nominees: 5 Powerful Truths Behind South Africa’s Sporting Excellence
SA Sports Awards Nominees: 5 Powerful Truths Behind South Africa’s Sporting Excellence
The stage is set for one of South Africa’s most anticipated nights in sport. Minister Gayton McKenzie has officially unveiled the list of nominees for the 18th South African Sport Awards, marking a celebration of athletic achievement, dedication, and national pride. Set to take place on Sunday, 24 August at the iconic Sun City Superbowl, this year’s ceremony promises to honor the men and women who have represented the nation with distinction on local and global stages.
The SA Sports Awards nominees reflect the depth and diversity of talent across disciplines from track and field to football, swimming to netball, and emerging sports like esports. As the public begins to weigh in on who deserves recognition, the awards also serve as a powerful reminder of sport’s role in uniting communities, inspiring youth, and shaping national identity.
SA Sports Awards Nominees: A Night of National Celebration
The South African Sport Awards are more than a glamorous event they are a tribute to perseverance, discipline, and excellence. Each nominee has overcome challenges, broken records, and brought honor to their teams, provinces, and country. Their journeys often marked by limited resources, personal sacrifice, and immense pressure resonate deeply with millions of South Africans.
Minister McKenzie emphasized the importance of public participation, urging citizens to vote for their favorites. This democratic element ensures that the awards are not only a government initiative but a people’s celebration a moment where fans become part of the story.
When Heroes Are Chosen by the People
As highlighted in Mauritius Times – The issue with parliamentary pensions is not whether they’re contributory, but the age of eligibility, “Government must act to show that the same criteria apply equally to all.” Similarly, recognition in sport should be fair, transparent, and inclusive and public voting ensures that every voice counts.

Truth #1: Excellence Deserves Recognition
One of the most powerful truths about the SA Sports Awards nominees is that greatness should not go unnoticed. Behind every medal, record, or championship is hours of training, sacrifice, and resilience. These awards shine a light on those who push the limits of human potential.
Whether it’s a sprinter breaking national records or a coach transforming lives in a township, recognition fuels motivation and sets new benchmarks for future generations.
Awarding Merit Builds National Confidence
As seen in other global issues from Queen kaMayisela’s attempt to interdict a royal wedding to Archbishop Makgoba rejecting fake news when institutions act with integrity, public trust grows.
Truth #2: Sport Unites a Nation
In a country marked by diversity and historical divisions, sport has a unique power to bring people together. When Bonginkosi Madikizela crosses the finish line or when the Proteas win a crucial match, the entire nation celebrates regardless of race, language, or background.
The SA Sports Awards nominees represent more than individual success they symbolize unity in action.
Victory Wears the Colors of South Africa
As noted in SABC News – The man suspected to have abducted and raped two nurses has been arrested, “Public trust is fragile and it must be earned.” The same applies to national pride: it is earned through shared moments of triumph.
Truth #3: Youth Need Role Models
For young South Africans facing unemployment, crime, and limited opportunities, athletes serve as powerful role models. Seeing a fellow citizen succeed on the world stage sends a clear message: “If they can do it, so can I.”
The SA Sports Awards nominees inspire dreams, encourage discipline, and show that with hard work, even the most distant goals are within reach.
Dreams Are Built on Examples
When a child in Soweto picks up a football after watching a Bafana Bafana star, the cycle of inspiration continues.
Truth #4: Inclusion Strengthens Sport
This year’s list of SA Sports Awards nominees includes athletes from a wide range of backgrounds, genders, and disabilities. The recognition of para-athletes, women in sport, and grassroots champions reflects a growing commitment to equity and inclusion.
True sporting excellence is not limited to one group, it emerges from every corner of the nation, and the awards must reflect that reality.
Opportunity Should Know No Boundaries
As highlighted in Mauritius Times – The issue with parliamentary pensions is not whether they’re contributory, but the age of eligibility, “The issue with accountability is not whether systems exist, but whether they are enforced.” The same applies to inclusion: if access is not equal, excellence is stifled.
Truth #5: This Is More Than a Ceremony , It’s a Movement
The SA Sports Awards nominees event is not just about handing out trophies , it’s about building a culture of excellence, accountability, and national pride. It challenges sports federations to invest in talent, calls on sponsors to support athletes year-round, and reminds government of its role in developing infrastructure and access.
Every vote cast is a statement: “We believe in our athletes. We believe in our future.”
Sport Is the Heartbeat of the Nation
When the anthem plays and the flag rises, it’s not just a win , it’s a moment of unity.
Conclusion: A Celebration of Who We Are and Who We Can Be
The SA Sports Awards nominees are more than a list , they are a mirror of South Africa’s spirit. They reflect resilience, diversity, and the unyielding pursuit of greatness. As the nation prepares to gather in Sun City and across living rooms, the message is clear: our athletes are not just competitors , they are national treasures.
So, who will you vote for? The answer is not just about preference , it’s about values. It’s about honoring those who make us proud, inspire our children, and remind us of what’s possible when talent meets opportunity.
For deeper insights on governance and national development, read our analysis: Good Governance in South Africa – Challenges and Solutions.